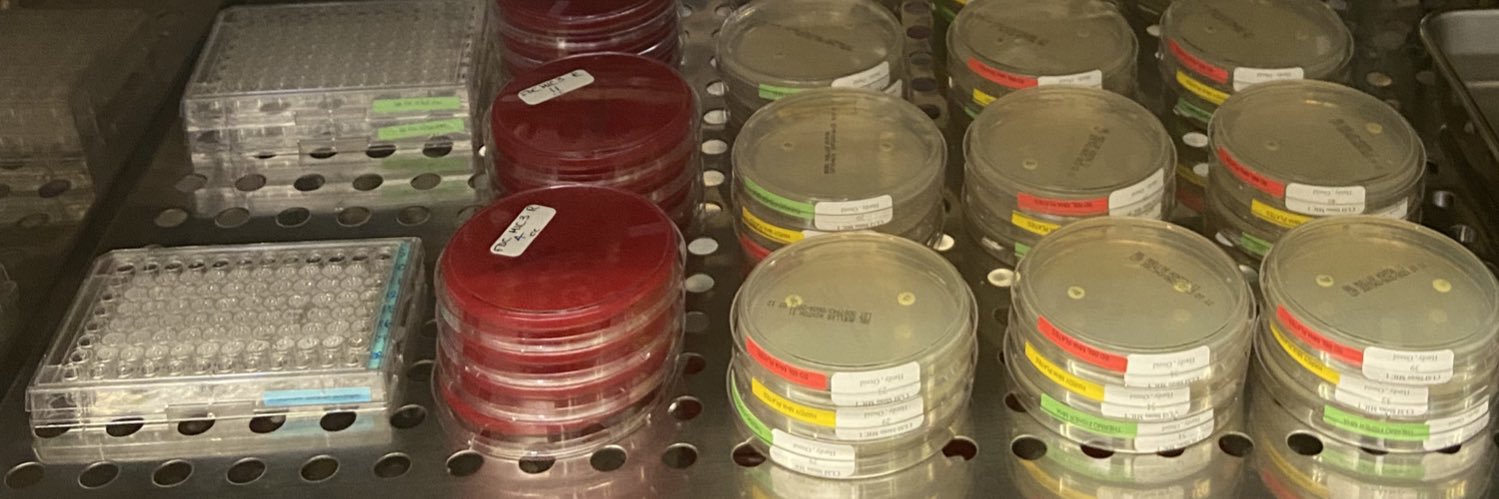
Andrew Fratoni banner

Andrew Fratoni
4K posts

Andrew Fratoni
@AFratty
Pharmacist. Associate Director, Clinical and Laboratory Studies at CAIRD, Hartford Hospital. Thoughts are my own. He/him #UConn #FinsUp #PinstripePride


🆕️⚡️⚡️#JAC from Dr.Nicolau Hartford group Ampicillin-sulbactam against Acinetobacter baumannii infections: pharmacokinetic/pharmacodynamic appraisal of current susceptibility breakpoints and dosing recommendations #IDXposts academic.oup.com/jac/article-ab…

Non-KPC Attributes of Newer β-lactam/β-lactamase Inhibitors, Part 1: Enterobacterales and Pseudomonas aeruginosa bit.ly/3Y8N7bC




In vitro-in vivo discordance in β-lactams activities against MBL producing Enterobacterales has been described 🔥Deciphering the Efficacy of β-Lactams in the Face of MBL Derived Resistance in Enterobacterales Supraphysiologic Zinc in Broth is the Culprit🔥 academic.oup.com/ofid/article/d…



Dan Hurley. The Carpenter.

@Floralquinolone Not sure if here is the best place to tag on but, Hartford Hospital is going into Phase II for our ID PGY-2 program. If anyone is interested in hearing more about the program, feel free to send me a DM as a previous-resident turned preceptor!!

Beta-lactam TDM on your mind? Register today for this live CE webinar to learn more about optimizing TDM for this class of antibiotics! Visit buff.ly/3uRyMUC to learn more.




Non-KPC Attributes of Newer β-lactamase/β-lactamase Inhibitors, Part 1: Enterobacterales and Pseudomonas aeruginosa ✅ Just Accepted 🔗 bit.ly/3UxkT8u



Are you considering a PGY2 in Infectious Diseases 🦠? We’re interviewing at PPS this week and would love to meet you! #PharmRes #TwitteRx #ASHP23



Register today for a free live CE webinar on Tuesday, November 14th, 2023, 12:00 pm – 1:00 pm CT/1:00 pm – 2:00pm ET with Barbara Santevecchi, PharmD, BCPS, BCIDP and Tomefa Asempa PharmD! 1.0 hours of ACPE credit available 💻🦠 Register at: sidp.org/SIDPEC

